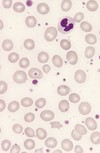
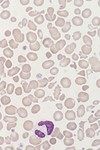
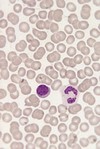
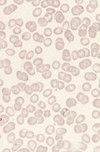
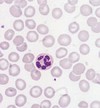
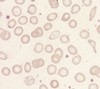
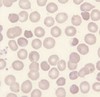
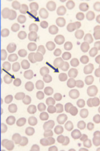
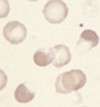
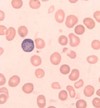

Physiology of blood cells and haematological terminology Flashcards
(30 cards)
Where do blood cells originate from?
Multipotent haemopoietic stem cells => give rise to lymphoid/myeloid stem cells => RBC, granulocytes, monocytes and platelets
Describe the stem cell hierarchy

Essential characteristics of stem cells
> Ability to self-renew and produce mature progeny
(Divide into 2 cells, a stem cell and one capable of differentiating to mature progeny)
What does a myeloid stem cell give rise to?
Proerythroblast which gives rise to erythroblasts and then erythrocytes/RBC
What stage is this cell in regards to normal erythroid maturation?

Proerythroblast
What stage is this cell in regards to normal erythroid maturation?

Early Erythroblast
What stage is this cell in regards to normal erythroid maturation?

Intermediate erythroblast
What stage is this cell in regards to normal erythroid maturation?

Late erythroblast
A requirement for erythropoiesis?
Presence of erythropoietin
(synthesis of erythropoietin is mainly conducted in the kidneys in response to hypoxia)
Outline the synthesis of erythropoietin
90% from Juxtatubular interstitial cells in the KIDNEY
10% from hepatocyte and interstitial cells in the LIVER
Both diffuse into the capillaries
Function, survival and destruction of RBCs
Red blood cells survive about 120 days in the blood system
Involved in O2 and CO2 transport
Destroyed by phagocytic cells in the spleen
What do myeloblast cells give rise to? and what is needed?
Granulocytes and monocytes
(Cytokines, G-CSF, M-CSF, GM-CSF and GM-CSF and other interleukins)
What are the stages of normal granulocyte maturation?
Myeloblast => Promyelocyte => Myelocyte => Band form => Neutrophil
Function and survival of neutrophil granulocytes
Defence against infection through phagocytosis of micro-organisms
Survives for 7-10hrs in circulation before moving into tissues
Outline the movement of neutrophils into tissue
- Adhesion and margination
- Rolling
- Diapedesis (move through capillaries, normally accompanied with inflammation)
- Migration
- Phagocytosis
Function and development of the eosinophil granulocytes
Defence against parasitic infection
Develops from myeloblast stem cells
(stays in circulation for less time than neutrophils)
Function and development of the basophil granulocytes
Involved in allergic responses
Develops from myeloblast stem cells
Function and development of the monocyte
Arises from the myeloid stem cell through monocyte precursors
Develop into macrophages in tissue and other specialised cells with scavenging and phagocytic properties
Store Iron and remain in circulation for days
Survival, function and development of platelets
Survive 10 days in circulation
Involved in primary haemostasis, contribute phospholipids which promotes blood coagulation
Haemopoietic stem cells => megakaryocytes => platelets
Lymphocytes and their circulation
T/B/NK cells derive from lymphoid stem cells
The recirculate to lymph node/tissues before entering the bloodstream
Anisocytosis
RBC show abnormal variations in size
Poikilocytosis and types (6)
RBC show abnormal variations in shape
Spherocytes, Irregularly contracted cells, Sickle cell, Target cells, Elliptoctyes, Fragments
Microcytosis
RBC are smaller than normal
Macrocytosis and types

RBC are large than normal
can be round, oval or polychromatic